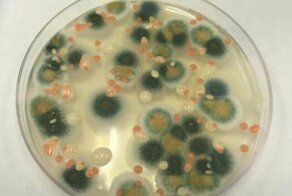

2289
5
Останки крокодила, жившего 180 млн лет назад, были найдены в Баварии в 1770-х годах. Лишь спустя 250 лет эксперты смогли определить, что перед ними представитель вымершего вида мистриозавров (Mystriosaurus laurillardi).
Обнаруженный вид жил в тропических лесах во времена юрского периода
Эти крокодилы обладали длинной мордой и острыми зубами, питались рыбой. Максимальная длина тела составляла 4,5 м.
×
Мистриозавры плавали в теплых морях, соседствуя с другими животными, включая аммонитов и крупных морских рептилий - ихтиозавров
Команда, в которую вошли эксперты Эдинбургского университета, установила, что еще один череп, обнаруженный в Йоркшире в 1800-х годах, также принадлежит виду Mystriosaurus laurillardi.
Окаменелости, найденные в Германии и Великобритании, свидетельствуют о том, что вид мог переплывать между островами
Руководитель исследования Сфен Захс из Билефельдского музея естествознания рассказал: "Мистриозавр был похож на гавиала, но у него была более короткая морда с носовыми отверстиями, обращенными вперед, в то время как почти у всех других ископаемых и современных крокодилов ноздри размещены на верхней части головы".
Исследование опубликовано в журнале Acta Palaeontologica Polonica.
Исследование опубликовано в журнале Acta Palaeontologica Polonica.
Реконструкция морды мистриозавра
Разнообразие крокодилов, обитавших 200-180 млн лет назад, пока еще мало изучено.
Источник: — переведено специально для fishki.net
Ссылки по теме:
- Чернобыль: в ядерном реакторе растет гриб, который не боится радиации и, кажется, "питается" ею
- В Австралии найден новый вид паука-скакуна, напоминающий шедевр Ван Гога
- Попугай Дракула: самая готичная птица планеты
- Вселенная может состоять из частиц, а не полей || [Теория поля Белла: 2 часть]
- Вселенная может состоять из частиц, а не полей | [Теория поля Белла: 1 часть]